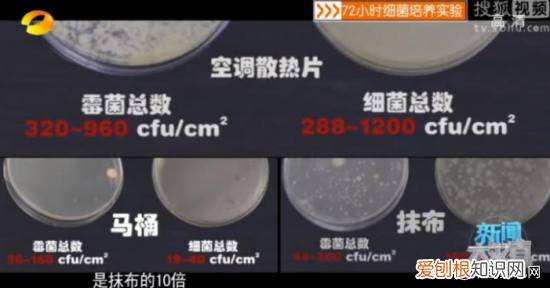
空调扇到底有没有用？空调扇的制冷效果怎么样

文章插图

文章插图

文章插图
一年一度的高温天气来临了,炎热的天气极其容易晒伤皮肤,因此大家都纷纷换上遮阳和透气的清凉衣服 。高温的负面作用不止如此,心情也很容易被影响的十分焦躁,降低我们工作和学习的效率 。不过处于现代社会,怎么能没有解决措施呢?各类现代科技家电,就是让我们在这炎炎夏日能够享受到一抹清凉的助攻 。
【空调扇到底有没有用?空调扇的制冷效果怎么样】电风扇可谓是大家的老朋友,八九十年代,家家户户都会购买电风扇来消暑纳凉 。不过对上这三四十度的天气,它便显得不太够用 。虽然它可以“摇头”调节角度,但风感生硬,吹多了很容易导致头疼 。而且在开启时噪音比较大,对于睡眠轻的人来说反而是种折磨 。对于家庭有小孩的人来说,风罩设计也较为危险,总有淘气的孩子想将手指伸进去,而且相对空调来说它的风速风力太小 。

文章插图

文章插图
不过,虽然空调可以有效降温,但如此一来,我们无法经常通风 。室内通风不畅会让空气的湿度过大,家具也容易滋生霉菌导致过敏,而且当外出归来毛孔还处于张开的散热状态,直接吹空调的话,毛孔接触到冷空气会马上收缩,使热量无法排出,身体会感到不舒服,我们一般称之为空调病 。
文章插图

文章插图
不仅如此,不知你家的空调多久清洗一次呢?由于空调的结构,大多数人家都很少清洗空调,而根据湖南卫视《新闻大求真》的节目,测试过的未清洗的空调、马桶与抹布数据对比发现,空调散热片的细菌含量竟然是马桶的60倍,抹布的10倍!所以如果你从不清洁空调,还经常吹凉风的话,很容易会身体不适哦!

文章插图

文章插图
想必是家电厂商听到了我的需求,推出了一种名为“空调扇”的产品 。没用过的朋友一定很疑惑,这俩东西也能相互结合?在这里,我要出来澄清一番,其实空调扇与空调没有丝毫关系,它就是装了水冷装置的电风扇 。没有压缩机,也不用氟利昂,通过冰晶来释放冷气让水降温,再将水汽释放到水帘上 。是兼具送风、制冷、加湿等功能于一身的一种家用电器 。
那么它如何降温呢?主要是通过以下两种方式 。
一、 布帘滚动式降温
将水箱里的水抽至水箱顶部再从湿帘布顺势流下,之后通过直流无刷电机驱动叶轮将经过湿帘布降温的空气吹至我们身边 。
二、 冰晶蓄冷式降温
这类空调扇是水泵将冰水抽上来浸湿冰帘,热空气吸入之后通过冰帘变成冷空气,再由贯流风吹出冷风 。这种方式因为有冰晶,能很好地降低空气的温度,如果是加入冰水会更加凉快,效果也比其他类型要好一些 。
虽然它没有空调能那么凉快,但是效果相比电风扇还是强了不只一星半点 。相对空调来说,耗电量更低,价格也便宜,还符合环保健康要求,避免得空调病的隐患,体积较小,可以随意移动 。它倒是也有缺点,受到覆盖面的限制,大空间制冷一定感觉不强烈,但如果是卧室使用还是绰绰有余 。
推荐阅读
- 1.5匹空调多少瓦?功率一般在1180-1300W之间
- 砂锅第一次用需要怎么处理?教你1招,砂锅耐用顺手不开裂
- 做到4点,长的漂亮又精致 金枝玉叶花的养殖方法和注意事项
- 9个步骤按部就班,装出满分新房 装修房子的步骤流程
- oppo手机怎么样,oppo手机有哪些优缺点?
- 净水器哪个牌子好?最具有性价比的七款净水器
- 都说买房要避开“槽钢层” 槽钢层是什么意思
- 教你1招,不用洗不用晒 床上除螨虫的最快方法
- 三八妇女节小礼物推荐 三八妇女节礼品推荐
